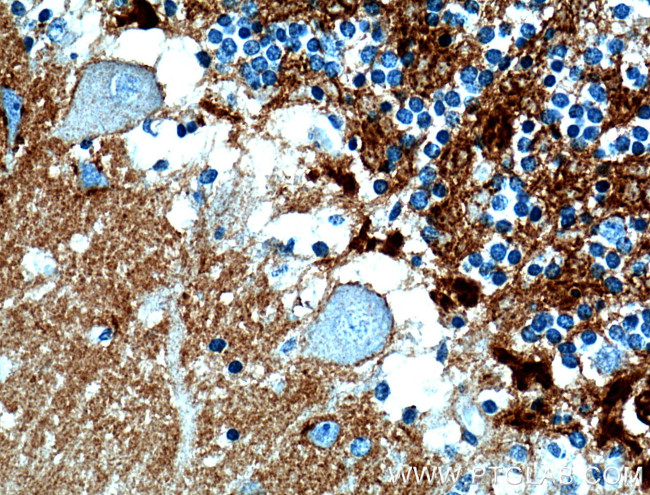
Brevican Antibody in Immunohistochemistry (Paraffin) (IHC (P))

Search
Proteintech
Brevican Polyclonal Antibody
{{$productOrderCtrl.translations['antibody.pdp.commerceCard.promotion.promotions']}}
{{$productOrderCtrl.translations['antibody.pdp.commerceCard.promotion.viewpromo']}}
{{$productOrderCtrl.translations['antibody.pdp.commerceCard.promotion.promocode']}}: {{promo.promoCode}} {{promo.promoTitle}} {{promo.promoDescription}}. {{$productOrderCtrl.translations['antibody.pdp.commerceCard.promotion.learnmore']}}






Please note: We are reviewing Western blot images included in the antibody testing data in our catalog, including those provided by third parties. Unless expressly labeled or annotated as “raw-unedited”, Western blot images included in the antibody testing data in our catalog may have been edited, optimized or otherwise adjusted for presentation.
产品信息
19017-1-AP
种属反应
宿主/亚型
分类
类型
抗原
偶联物
形式
浓度
规格
纯化类型
保存液
内含物
保存条件
运输条件
产品详细信息
Immunogen sequence: LEGDSSEDR AFRVRIAGDA PLQGVLGGAL TIPCHVHYLR PPPSRRAVLG SPRVKWTFLS RGREAEVLVA RGVRVKVNEA YRFRVALPTY PASLTDVSLA LNELRPNDSG IYRCEVQHGI DDSSDAVEVK VKGVVFLYRE GSARYAFSFS GAQEACARIG AHIATPEQLY AAYLGGYEQC DAGWLSDQTV RYPIQTPREA CYGDMDGFPG VRNYGVVDPD DLYDVYCYAE DLNGELFLGD PPEKLTLEEA RAYCQERGAE IATTGQLYAA WDGGLDHCSP GWLADGSVRY PIVTPSQRCG GGLPGVKTLF LFPNQTGFPN KHSRFNVY (23-350 aa encoded by BC010571 )
靶标信息
Brevican is the most abundant chondroitin sulfate proteoglycan in the extracellular matrix of the adult brain. It is a member of the lectican family of aggregating extracellular matrix proteoglycans that bear chondroitin sulfate (CS) chains. It is highly expressed in the central nervous system and is thought to stabilize synapses and inhibit neural plasticity. Brevican is secreted from astrocytes and neurons as a 145 kD core protein that bears up to three, covalently-linked, CS chains. It is also is secreted as a 145 kD core protein without CS chains. When cleaved by extracellular glutamyl endopeptidases, the ADAMTSs, a 55 kD N-terminal fragment is formed that contains the unique C terminal epitope EAMESE.
仅用于科研。不用于诊断过程。未经明确授权不得转售。
篇参考文献 (0)
生物信息学
蛋白别名: BEHAB; Brain-enriched hyaluronan-binding protein; brevican (brain specific proteoglycan in the aggrecan family); Brevican core protein; Chondroitin sulfate proteoglycan 7
基因别名: ALPBRE; BCAN; BEHAB; CSPG7; UNQ2525/PRO6018
UniProt ID: (Rat) P55068, (Mouse) Q61361
Entrez Gene ID: (Rat) 25393, (Mouse) 12032